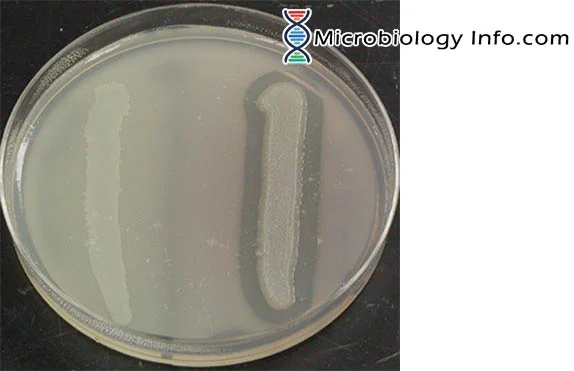
<p>Right side (Clearing in agar around growth)</p>

1/25
Looks like no tags are added yet.
Name | Mastery | Learn | Test | Matching | Spaced | Call with Kai |
|---|
No analytics yet
Send a link to your students to track their progress
Lipase is positive?
Right side (Clearing in agar around growth)
Decarboxylase is present
Purple
Decarboxylase is not present
Yellow
Catalase is positive
Bubbles
Starch is positive
Had a cleaning of medium (a straight line down the middle)
Acid fast
Presence of mycolic acids
Citrate Utilization Test: Blue
Citrate is utilized (+)
Citrate utilization test: No color change, no growth
Citrate is utilized (citrate permeate is present)
Citrate utilization test: No color change no; growth
Citrate is not utilized (citrate permease is absent or not detectable)
Phenol Red Fermentation; yellow broth, bubble in tube
Fermentation of the specific carbohydrate with acid and gas products
Phenol Red Fermentation; yellow broth, no bubble in tube
Fermentation of the specific carbohydrate with acid end products; no gas product, or gas produced in undetectable amounts
Phenol Red Fermentation; Pink broth, no bubble
Degradation of peptone, alkaline end products
Methyl red test results: Red
Organism performs a mixed acid fermentation
Methyl red test results: Orange or pink
Organism does not perform a mixed acid fermentation or then end products are not made in detect-able amounts
Votes-Proskauer Test: Red or Pink
Organism performed a 2,3 butanaedoil fermentation (action produced)
Votes-Proskauer Test: No color change
Organism does not perform a 2,3-butanediol fermentation

Sulfur reduction test: Black in the medium
Sulfur reduction (H2S production); organism either respires anaerobically with sulfate as the final electron acceptor or hydrolysis the amino acid cysteine (+)

Sulfur reduction test: No black in the medium
Sulfur is not reduced, or is not reduced in detectable amounts (-)

Insole production test: Red in the alcohol layer of Kovac’s regent
Organism produces tryotophanase and hydrolyzes tryptophan into indlolr and pyrubate (+)

Insole production test: Reagent color is unchanged
Tryptophanase is absent and indoor is not produced or is produced but not in recreate amounts (-)
Motility Test: Growth radiating outward from stab line
Motility (+)
Motility test: No radiating growth
Nonmotile (-)
Motility test: Blackened medium
Motility not determined
Lipase is absent
No clearing in agar around the growth
Gelatin Hydrolysis Test: Positive
Gelatinase is liquid. Gelatinase is present
Gelatin Hydrolysis Test: Negative
Gelatinase is sold. Gelatinnase is absent or nor detectable